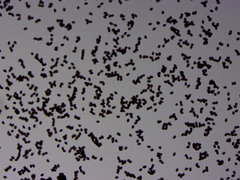
Cortinarius lilacinus

Cortinarius lilacinus: taxon details and analytics
- Domain
- Kingdom
- Fungi
- Phylum
- Basidiomycota
- Class
- Agaricomycetes
- Order
- Agaricales
- Family
- Cortinariaceae
- Genus
- Cortinarius
- Species
- Cortinarius lilacinus
- Scientific Name
- Cortinarius lilacinus
Images from inaturalist.org observations:
We recommend you sign up for this excellent, free service.
Parent Taxon
Sibling Taxa
- Alboaggregati
- Anomali
- Archeriani
- Aureocistophili
- Austrocyanites
- Austrovaginati
- Bolares
- Caerulescentes
- Caesiocortinati
- Callistei
- Callochroi
- Camphorati
- Carbonelli
- Chrysmatum
- Claricolores
- Cortinarius
- Cortinarius abietinus
- Cortinarius abnormis
- Cortinarius absarokensis
- Cortinarius acystidiosus
- Cortinarius adonis
- Cortinarius aegrotus
- Cortinarius aggregatus
- Cortinarius ainsworthii
- Cortinarius albidolilacinus
- Cortinarius albidus
- Cortinarius albofragrans
- Cortinarius alboluteus
- Cortinarius alboroseus
- Cortinarius alborufescens
- Cortinarius alienatus
- Cortinarius allutus
- Cortinarius alnetorum
- Cortinarius amabilis
- Cortinarius amnicola
- Cortinarius amoenus
- Cortinarius amurceus
- Cortinarius anfractus
- Cortinarius anisodorus
- Cortinarius anocorium
- Cortinarius anserinus
- Cortinarius appalachiensis
- Cortinarius aquilanus
- Cortinarius araneosovolvatus
- Cortinarius arcifolius
- Cortinarius ardesiacus
- Cortinarius areolatoimbricatus
- Cortinarius argentatus
- Cortinarius argenteopileatus
- Cortinarius armeniacovelatus
- Cortinarius assiduus
- Cortinarius athabascus
- Cortinarius atkinsonianus
- Cortinarius atrolazulinus
- Cortinarius atropusillus
- Cortinarius aurantiacoides
- Cortinarius aurantiellus
- Cortinarius aurantioferreus
- Cortinarius aurantiomarginatus
- Cortinarius aurantiorufus
- Cortinarius aureifolius
- Cortinarius aureopigmentatus
- Cortinarius aurescens
- Cortinarius austrocausticus
- Cortinarius austrocinnabarinus
- Cortinarius austrolimonius
- Cortinarius austrosaginus
- Cortinarius austrosalor
- Cortinarius austroviolaceus
- Cortinarius autumnalis
- Cortinarius badiolatus
- Cortinarius badius
- Cortinarius basililaceus
- Cortinarius basipurpureus
- Cortinarius basiroseus
- Cortinarius basorapulus
- Cortinarius bellus
- Cortinarius betuletorum
- Cortinarius biriensis
- Cortinarius blattoi
- Cortinarius boreidionysae
- Cortinarius boyacensis
- Cortinarius britannicus
- Cortinarius brunneiaurantius
- Cortinarius brunneofulvus
- Cortinarius brunneolimosus
- Cortinarius brunneotinctus
- Cortinarius bulbopodius
- Cortinarius bulbosus
- Cortinarius caesiocyaneus
- Cortinarius californicus
- Cortinarius caligatus
- Cortinarius callimorphus
- Cortinarius calojanthinus
- Cortinarius calyptratus
- Cortinarius calyptrodermus
- Cortinarius canarius
- Cortinarius cardinalis
- Cortinarius carneoroseus
- Cortinarius caroviolaceus
- Cortinarius carranzae
- Cortinarius cartilagineus
- Cortinarius caryae
- Cortinarius casimirii
- Cortinarius castaneiceps
- Cortinarius castaneicolor
- Cortinarius cavipes
- Cortinarius cereifolius
- Cortinarius chlorophanus
- Cortinarius chrysopocos
- Cortinarius citrino-olivaceus
- Cortinarius citriolens
- Cortinarius clarobaltoides
- Cortinarius cliduchus
- Cortinarius coeruleopallescens
- Cortinarius coerulescentium
- Cortinarius colombianus
- Cortinarius comatus
- Cortinarius conicus
- Cortinarius contrarius
- Cortinarius contulmensis
- Cortinarius costaricensis
- Cortinarius cramesinus
- Cortinarius cretaceus
- Cortinarius cruentipellis
- Cortinarius cruentiphyllus
- Cortinarius cruentus
- Cortinarius crustulinus
- Cortinarius crystallinus
- Cortinarius cunninghamii
- Cortinarius cupreonatus
- Cortinarius cyaneus
- Cortinarius cyanopus
- Cortinarius cylindripes
- Cortinarius damascenus
- Cortinarius deceptivus
- Cortinarius depressus
- Cortinarius diabolicoides
- Cortinarius diaphorus
- Cortinarius dionysae
- Cortinarius distans
- Cortinarius dombeyi
- Cortinarius duracinellus
- Cortinarius effundens
- Cortinarius elacatipus
- Cortinarius elegantulus
- Cortinarius emunctus
- Cortinarius erythraeus
- Cortinarius erythrinus
- Cortinarius esculentus
- Cortinarius eucaeruleus
- Cortinarius eunomalus
- Cortinarius exlugubris
- Cortinarius fagetorum
- Cortinarius favrei
- Cortinarius firmus
- Cortinarius fistularis
- Cortinarius flavescentipes
- Cortinarius flavidolilacinus
- Cortinarius flavidulus
- Cortinarius flavipallens
- Cortinarius flavivelatus
- Cortinarius flavoaurantians
- Cortinarius flavobulbus
- Cortinarius flos-paludis
- Cortinarius fragilis
- Cortinarius fragrantior
- Cortinarius fulmineus
- Cortinarius fulvosquamosus
- Cortinarius furfuraceus
- Cortinarius fuscobovinaster
- Cortinarius fuscobovinus
- Cortinarius fuscotinctus
- Cortinarius fusisporus
- Cortinarius gayi
- Cortinarius gentianeus
- Cortinarius glaucocephalus
- Cortinarius glaucocyanopus
- Cortinarius glaucopoides
- Cortinarius glutinosoarmillatus
- Cortinarius glutinosus
- Cortinarius gracilior
- Cortinarius hadrocroceus
- Cortinarius heatherae
- Cortinarius hebelomaticus
- Cortinarius heliotropicus
- Cortinarius helobius
- Cortinarius hiemalis
- Cortinarius hinnuloides
- Cortinarius hoeftii
- Cortinarius holophaeus
- Cortinarius hydrotelamonioides
- Cortinarius iliopodius
- Cortinarius immixtus
- Cortinarius impennis
- Cortinarius incisus
- Cortinarius incognitus
- Cortinarius indolicus
- Cortinarius inexspectatus
- Cortinarius inops
- Cortinarius intricatus
- Cortinarius iodeoides
- Cortinarius iodes
- Cortinarius ionomataius
- Cortinarius isabellinus
- Cortinarius jenolanensis
- Cortinarius jonimitchelliae
- Cortinarius jubarinus
- Cortinarius kaputarensis
- Cortinarius kauffmanianus
- Cortinarius kytoevuorii
- Cortinarius lamproxanthus
- Cortinarius latobalteatus
- Cortinarius latus
- Cortinarius lazulinus
- Cortinarius lebre
- Cortinarius lebretonii
- Cortinarius lepidopus
- Cortinarius lepistoides
- Cortinarius leucopus
- Cortinarius levisporus
- Cortinarius lewisii
- Cortinarius lignarius
- Cortinarius lilacinocolossus
- Cortinarius lilacinus
- Cortinarius livido-ochraceus
- Cortinarius luhmannii
- Cortinarius luteiaureus
- Cortinarius luteirufescens
- Cortinarius luteoarmillatus
- Cortinarius luteobrunneus
- Cortinarius luteoimmarginatus
- Cortinarius luteopulveratus
- Cortinarius luteus
- Cortinarius maculobulga
- Cortinarius maculosus
- Cortinarius magellanicoalbus
- Cortinarius magisporus
- Cortinarius mahiquesii
- Cortinarius majoranae
- Cortinarius majusculus
- Cortinarius malosinae
- Cortinarius mastoideus
- Cortinarius medioscaurus
- Cortinarius melimyxa
- Cortinarius melliolens
- Cortinarius memoria-annae
- Cortinarius metrodii
- Cortinarius mexicanus
- Cortinarius minilacus
- Cortinarius minorisporus
- Cortinarius minoscaurus
- Cortinarius mucifluoides
- Cortinarius multiformium
- Cortinarius musciphilus
- Cortinarius myrtilliphilus
- Cortinarius myxenosma
- Cortinarius myxo-anomalus
- Cortinarius nahuelbutensis
- Cortinarius naphthalinus
- Cortinarius nebulobrunneus
- Cortinarius neotropicus
- Cortinarius nigrosquamosus
- Cortinarius nivalis
- Cortinarius nothoanomalus
- Cortinarius obtusorum
- Cortinarius obvius
- Cortinarius ochraceofulvus
- Cortinarius ochribubalinus
- Cortinarius ochroglutinosus
- Cortinarius odhinnii
- Cortinarius olens
- Cortinarius oleosus
- Cortinarius olidoamarus
- Cortinarius olidoamethysteus
- Cortinarius olidus
- Cortinarius olivaceodionysae
- Cortinarius olivascentium
- Cortinarius oliveopetasatus
- Cortinarius olorinatus
- Cortinarius opaculus
- Cortinarius ophiopus
- Cortinarius opimus
- Cortinarius orixanthus
- Cortinarius palatinus
- Cortinarius pallidifolius
- Cortinarius papaver
- Cortinarius paralbocyaneus
- Cortinarius paraoniti
- Cortinarius paraonui
- Cortinarius paraxenosma
- Cortinarius pectochelis
- Cortinarius pellstonianus
- Cortinarius peraureus
- Cortinarius peraurilis
- Cortinarius perelegans
- Cortinarius perfoetens
- Cortinarius periclymenus
- Cortinarius permagnificus
- Cortinarius perplexus
- Cortinarius persicanus
- Cortinarius perviolaceus
- Cortinarius peumo
- Cortinarius phaeochlorus
- Cortinarius phalarus
- Cortinarius pholiotellus
- Cortinarius pinetorum
- Cortinarius pini
- Cortinarius pinophilus
- Cortinarius piriformis
- Cortinarius pluviorum
- Cortinarius poecilopus
- Cortinarius polymorphus
- Cortinarius ponderosus
- Cortinarius poppyzon
- Cortinarius porphyrophaeus
- Cortinarius praefelleus
- Cortinarius pratensis
- Cortinarius privignipallens
- Cortinarius privignoides
- Cortinarius pseudoarcuatorum
- Cortinarius pseudorotundisporus
- Cortinarius pseudorubricosus
- Cortinarius pugionipes
- Cortinarius pulchellus
- Cortinarius pulchrifolius
- Cortinarius pustulatus
- Cortinarius putorius
- Cortinarius pyrophyllus
- Cortinarius quarciticus
- Cortinarius quercoarmillatus
- Cortinarius quercophilus
- Cortinarius radiofibrillosus
- Cortinarius rapaceus
- Cortinarius rarus
- Cortinarius regalis
- Cortinarius regis-romae
- Cortinarius rhizophorus
- Cortinarius rigidipes
- Cortinarius rigidiusculus
- Cortinarius rimosus
- Cortinarius roseipes
- Cortinarius roseolilacinus
- Cortinarius rubiginosus
- Cortinarius rubripes
- Cortinarius rubrobrunneus
- Cortinarius rufolatus
- Cortinarius rufoviolaceus
- Cortinarius rugosiceps
- Cortinarius sacchariosmus
- Cortinarius salicis
- Cortinarius salicis-rosmarinifoliae
- Cortinarius sancti-felicis
- Cortinarius sarcinochrous
- Cortinarius saturniorum
- Cortinarius savegrensis
- Cortinarius scandens
- Cortinarius sclerospermus
- Cortinarius scobinaceus
- Cortinarius scutulatus
- Cortinarius sebaceus
- Cortinarius serarius
- Cortinarius sericeus
- Cortinarius sertipes
- Cortinarius silvae-monachi
- Cortinarius simplex
- Cortinarius simulatus
- Cortinarius solis-occasus
- Cortinarius sordescentipes
- Cortinarius spadiceus
- Cortinarius sphaerocephalus
- Cortinarius sphagnogenus
- Cortinarius spisnii
- Cortinarius splendentium
- Cortinarius splendidus
- Cortinarius squalidiformis
- Cortinarius squamulosus
- Cortinarius squarrosus
- Cortinarius stemmatus
- Cortinarius sterilis
- Cortinarius strenuisporus
- Cortinarius subalboviolaceus
- Cortinarius subannulatus
- Cortinarius subarcheri
- Cortinarius subcaninus
- Cortinarius subcarneinatus
- Cortinarius subcroceofolius
- Cortinarius suberythrinus
- Cortinarius subferrugineus
- Cortinarius subflexipes
- Cortinarius subfoetidus
- Cortinarius subhygrophanicus
- Cortinarius sublargus
- Cortinarius subolivascens
- Cortinarius subpurpureophyllus
- Cortinarius subpurpureus
- Cortinarius subrimosus
- Cortinarius subrugulosus
- Cortinarius subsaniosus
- Cortinarius subsolitarius
- Cortinarius subsulfurinus
- Cortinarius subvalidus
- Cortinarius suillus
- Cortinarius symeae
- Cortinarius tabacinus
- Cortinarius teresae
- Cortinarius thiersianus
- Cortinarius thiersii
- Cortinarius tiliae
- Cortinarius triformis
- Cortinarius triumphans
- Cortinarius turbinatus
- Cortinarius turcopes
- Cortinarius umidicola
- Cortinarius ursus
- Cortinarius vagabundus
- Cortinarius vaginatus
- Cortinarius variegatus
- Cortinarius variipes
- Cortinarius velatus
- Cortinarius vellingae
- Cortinarius veraprilis
- Cortinarius veregregius
- Cortinarius vernalis
- Cortinarius vernicifer
- Cortinarius vinicolor
- Cortinarius violaceocinereus
- Cortinarius violaceoflavescens
- Cortinarius violaceovolvatus
- Cortinarius violilamellatus
- Cortinarius viridipileatus
- Cortinarius viscovenetus
- Cortinarius viscoviridis
- Cortinarius vitellinopes
- Cortinarius vulpinus
- Cortinarius wiebeae
- Cortinarius xenosma
- Cortinarius zinziberatus
- Crassi
- Cremeolinae
- Cretaces
- Cyanites
- Cycnei
- Delibuti
- Dermocybe
- Dulciolentes
- Elastici
- Entheosi
- Gigasperma
- Glaucopodes
- Ignelli
- Illumini
- Incensi
- Infracti
- Iodolentes
- Laquelli
- Leprocybe
- Liyuorum
- Lustrati
- Luteini
- Majestatici
- Malvacei
- Multiformes
- Myxacium
- Orellani
- Paramyxacium
- Paraxanthi
- Percomes
- Phlegmacium
- Protoglossum niveum
- Purpurelli
- Rapacea
- Riederi
- Rubicunduli
- Rubrobasales
- Salmasteri
- Scauri
- Sinapicolores
- Spilomei
- Subhymenogaster
- Subtorti
- Telamonia
- Thaumasti
- Turmales
- Verniciori
- Vibratiles
- Vinaceolamellati
- Walkeri